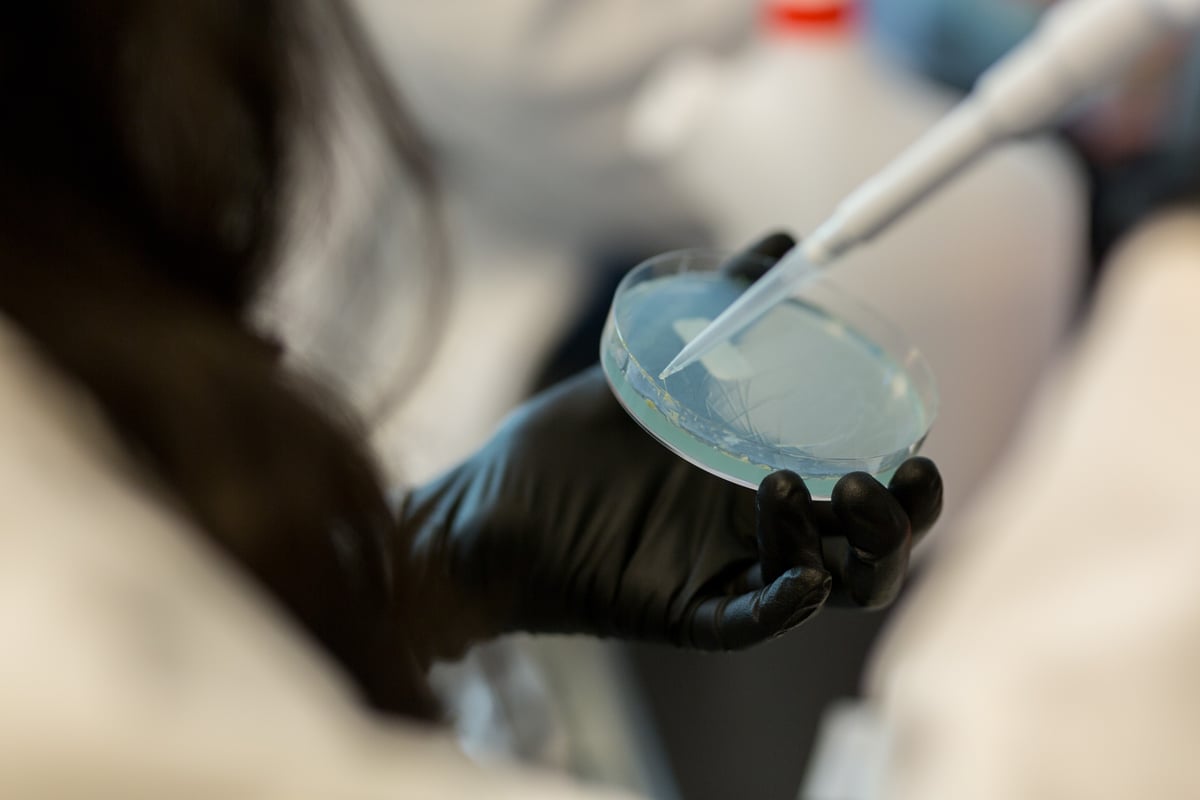
PivotBio Bakery 5-25-18 006

The complex relationships between microbes, their environment, and the crop is a mystery we’re just starting to unravel.
As a scientist, I am fascinated by the complexity of the world around me. The soil is no different. In one teaspoon of soil, there are millions of microbes all working together to produce an environment in which our crops are grown. Some of these microbes generate a healthy environment for the crops we grow, some do not. It’s my job to know which is which.
I am the senior scientist on Pivot Bio’s strain optimization team. My team examines microbes isolated from soil samples taken across the U.S. to determine the best way to cultivate a strain that can fix enough nitrogen to make a difference to our nitrogen hungry crops. We begin by getting to know the microbes, examining their genetic capabilities, and identifying areas where they could run more efficiently. Our team fine tunes hundreds of microbes, searching for the one that produces nitrogen the best.
It would be simple to assume that a microbe is just like a factory, where nitrogen gas goes in and ammonia comes out, but microbes are dependent on their environment. Like all of biology, they adapt and respond. My team works to ensure that our microbes operate at a high level in one very specific environment: the fields of modern agriculture.
One of the most exciting aspects of this research to me is our rapidly growing understanding of microbial diversity, and the roles they serve in agriculture. Microbes moderate the interaction between plant roots and their environment in many different ways. Some microbes help plants survive in salty soils. Some help plants survive droughts. Some can fend off plant pests. And some, like the microbes my team work with at Pivot Bio, provide nutrients to the growing plant just when they need them.
There’s another layer of complexity here too. Nitrogen is a highly reactive molecule, partnering with oxygen and hydrogen to become ammonia, nitrate, nitrite, and nitrous oxide. Sometimes it escapes back into the reservoirs of inert nitrogen that exist as mineralized organic matter in the soil or nitrogen gas in the atmosphere.
Agriculture makes use of ammonia and nitrate in a productive cycle. The plant takes up these forms of nitrogen and converts it into the proteins and pigments that enable plants to turn carbon dioxide into sugar and starch through photosynthesis. Over the course of a growing season, a consistent nitrogen source like Pivot Bio PROVEN™ means healthy crops and a good harvest for the farmer.
Nitrogen losses are bad for the farmer (or the home-owner who wants a green lawn!), but are hard to avoid with synthetic chemical fertilizer. The unintended consequences of nitrogen loss include algal blooms that pollute waterways, for example, or the release of nitrous oxide, a potent greenhouse gas. Microbes mediate nitrogen loss, using unique enzymes to transform nitrogen fertilizer into nitrogen that is easily lost to the environment. Understanding this web of interactions is key to developing the best possible nitrogen source for plants: nitrogen that is delivered where and when plants need it.
With millions of microbial species to discover and a web of interactions as intricate as any other ecosystem, I believe that I won’t ever find strain engineering boring! Embracing and exploring the complexity of the natural world is at the heart of what Pivot Bio does. I’m excited to lead a team dedicated to unraveling this mystery to provide farmers with the best tools available for crop nutrition.